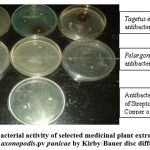

Introduction
The pomegranate tree is indigenous to the Mediterranean region of Asia, Africa, and Europe and can be found growing from Iran to the Himalayas in Northern India. It is considered as the “Fruit of Paradise” because it is most economically benificial and it shows various medicinal properties.1 Maharashtra, Karnataka, Andhra Pradesh, Rajasthan, Gujarat, and Tamil Nadu are among the Indian states where it is cultivated.2 In field this plant is susceptible to various diseases namely Anthracnose caused by Colletotrichum sp., Fruit blight caused by Alternaria sp., Leaf spot and fruit spot caused by Cercospora sp., Scab caused by Sphaceloma sp., wilt caused by Ceratocystis fimbriata and Fusarium axysporum and bacterial blight caused by Xanthomonas axonopodis pv. punicae. Among these blight disease of pomegranate caused by Xanthomonas axonopodis pv. punicae is more severe.3 The bacterial blight disease of pomegranate was first noticed in India, where the lack of efficient management techniques poses a serious danger to pomegranate farming. In India it is resulting in severe production losses of about 60–80% depending on disease severalty.1 In the year 2000, about 90% of Karnataka’s pomegranate cultivated land was damaged in the districts of Bagalkot, Belgaum, Bellary, Bijapur, Chitradurga, Gulburga, Koppal, Raichur, and Tumkur. 4
Xanthomonas axonopodis pv. punicae is non spore forming Gram negative rod shaped bacterium with single polar flagellum. It forms circular, smooth, glistening, light
yellow, mucoid, convex with entire margins colonies on nutrient glucose medium.5 It cause bacterial blight in pomegranate and it shows the initial symptoms that is appearance of water-soaked irregular to round, tiny black dots on leaves eventually develop a necrotic centre and turn to a dark brown colour. Spots can grow into a mass and create a large patch in severe cases, which may cause diseased leaves to fall off. On stem nodes, dark spot symptoms appear and begin cracking, easily break off the branches and cracking of fruits.6
Currently, streptomycin and copper oxy-chloride are being used to control bacterial blight disease.5 These chemicals are not economical and eco-friendly. Hence medicinal plants may be explored as one of the eco-friendly strategy for the control of bacterial blight disease of pomegranate. Some of the medicinal plants showed antibacterial activity against some plant pathogens. Bharadwaj and Laura in 2009 have reported that Xanthomonas campestris pv. campestris was inhibited by Acacia arabicae, Acacia catechu, Aegle marmelos, Asparagus racemosus, Achryanthus asper, Azadirachta indica, Callistemon lanceolatus and Acacia fernesiana.7 In this contest an attempt is made to study the antibacterial property of commonly availabletwo selected medicinal plants namely Tagetus erecta L. and Pelargonium graveolens against Xanthomonas axonopodis pv. punicae. Tagetus erecta L. popularly known as Marigold. Singh et al reported the wound healing, antibacterial, antimicrobial, antiepileptic, insecticidal, larvicidal, hepatoprotective, antipyretic and antifungal properties of Tagetus erecta L.8 Pelargonium graveolens commonly known as rose geranium.Hamidpour et al., reported the P. graveolens has shown antibacterial, antifungal , antioxidant and hypoglycemic activities.9
![]() |
Figure 1: Symptoms of Bacterial blight of pomegranate on (a) leaves, (b) stem and (c) fruit part |
Materials and Methods
Collection of diseased Punica granatum plant
Punica granatum (pomegranate) diseased plant was collected at the village Heggere, Challakere (Tq), Chitradurga (Dist.), Karnataka in January, 2022 and diseased plant leaves, stem and fruit parts were plucked from plant.
Koch’s postulates
The causal relationship between Xanthomonas axonopodis pv. punicae and Punica granatum was proved by Koch’s postulates.
Collection and Identification of Medicinal Plant Materials
The medicinal plants were collected from different parts of Chitradurga district. These plants include Tagetus erecta L. commonly known as Marigold and Pelargonium graveolens commonly known as lemon geranium in Doddasiddavanahally, Chitradurga, Karnataka, India. They are identified and authenticated by Dr. Lingannaiah and Prof. R. K. Rangaswamy, faculty of the Department of Botany, Government science college, Chitradurga using the gamble flora of Madras presidency.
Preparation of plant extracts
Fresh healthy leaves and flowers were collected from selected plants. They were washed individually once with under running tap water and with sterile water to get rid of dirt and other debris. The leaves and flower petals were shade dried at room temperature for 3-5 days in the laboratory. A fine powder of dried selected plant materials was made using pestle and mortar. The powdered plant material was stored at room temperature in air sealed polythene bags till the extract was prepared. 10
About 20 gm of selected plant material powders were immersed separately in solvents such as 100 ml of distilled water, ethyl alcohol and methyl alcohol for 24 hrs. After incubation, each soaked plant material was mixed vigorously and filtered through Whatmann filter paper no.1 and the filtrate was subjected to drying by rota evaporator. Then the plant leaf and flower extracts were used for in vitro antibacterial activity assay, phytochemical screening, minimum inhibitory concentration and minimum bacteriocidal concentrtaion studies.11
Preliminary phytochemical screening
The preliminary phytochemical studies were carried out by the accepted methods described by Kokate et al.11 with some changes. The leaf and flower extracts of Tagetus erecta L. commonly and Pelargonium graveolens were assayed for the detection of phytochemical constituents such as flavonoids, resins, proteins, terpenoids, glycosides etc.
Anti bacterial assay
Isolation of bacterial culture
The Xanthomonas axonopodis pv. punicae was isolated from diseased pomegranate plant material using nutrient agar. Diseased plant material is placed on sterilized nutrient agar medium plates and incubated at 37o C for one day. The isolated bacterium from Punica granatum is identified as Xanthomonas axonopodis pv. punicae based on Gram staining and biochemical tests.13
Preparation of bacterial inoculum
The Xanthomonas axonopodis pv. punicae isolated from punica granatum was identified as Xanthomonas axonopodis pv. punicae based on Gram staining and biochemical tests was cultured in nutrient broth and incubated for overnight at 37o C and centrifuged at 1000 rpm for 5 min. The bacterial pellet was collected and suspension was prepared using double distilled sterile water.
Preparation of Plant extracts discs
The sterilized Whatmann paper No.1 was cut into circular discs of 6 mm diameter. The discs were sterilized by autoclaving. The discs were soaked in plant extracts, dried and preserved at 4O C until further use.
Anti bacterial assay
The anti-bacterial activity was determined by Kirby-Bauer method. Nutrient agar medium plates were labeled with the name of plant extract to be placed and the bacterial culture to be inoculated. A volume of 0.1ml of Xanthomonas axonopodis pv. punicae suspension was placed on nutrient agar medium plates using sterile pipette and the inoculum was uniformly spread over agar surface using L-shaped glass rod. The presoaked and air dried plant extract discs were placed on their respective Petri plates. Standard antibacterial agent discs (Streptomycin and Copper oxychloride) which are used to control bacterial blight of pomegranate were placed in other bacterial plate. All the plates were incubated at 37oC for 24 hrs and the plates were visualized for the presence of zone of inhibition. The diameter of zone of inhibition was documented. The antibacterial activity test was performed in triplicates.
Minimum inhibitory Concentration (MIC)
The lowest concentration of the plant extract which shows no growth is visualized in the test tube is known as Minimum inhibitory concentration (bacteriostatic concentration). The MIC and MBC of selected plant extracts was detected by method described by Usman et al., (2007). The broth double serial dilution method was used to determine the MIC and MBC.13 The Tagetus erecta L. methanol extract was serially double diluted from 100 mg/ml to 6.25 mg/ml in nutrient broth medium.
A volume of 0.5 ml suspension of the test organism was inoculated to all the test tubes containing nutrient broth and plant extract in different concentration. After 24 hours of incubation at 37oC, the test tubes were looked for growth of bacteria. The calorimetric method was used to determine the growth of bacteria. The test tube containing plant extract at lowest concentration that inhibited the growth of the test organism completely (no turbidity) was the minimum inhibitory concentration (MIC) of the selected plant extracts.
Minimum Bactericidal Concentration (MBC)
The lowest concentration of plant extract where bacterial growth is not observed is known as MBC. This was determined by sub culturing the sample from broth dilutions of MIC tubes to nutrient agar medium. In this method, the sample from the MIC test tubes showing no turbidity was inoculated on sterile nutrient agar plates using a L-shaped glass rod and incubated at 37oC for 24 hours. The least concentration of the plant extract which did not showed bacterial growth on the inoculated nutrient agar plate was the MBC.
Results and Discussion
Phytochemical analysis: Latitude: 13.991, Longitude: 75.49815)
The preliminary phytochemical analysis of aqueous, ethanol and methanol extracts of Taget erecta L. and Pelargonium graveolens prepared in the year 2022 and stored at refrigerator until processed. It revealed the presence of alkaloids, flavonoids, tannins, resins, proteins, saponins, terpenoids, steroids and glycosides as shown table 1. The aqueous extracts of both Taget erecta L. and Pelargonium graveolens showed the presence of all tested phytochemical constituents.
Table 1: Phytochemical analysis of Tagetus erecta L. and Pelargonium graveolens extracts
| Sl.
No |
Active compound | Type of extracts | |||||
| Tagetus erecta L. extracts | Pelargonium graveolens extracts | ||||||
| Aqueous | Ethanol | Methanol | Aqueous | Ethanol | Methanol | ||
| 1. | Alkaloids | + | + | + | + | + | + |
| 2. | Flavanoids | + | + | + | + | + | + |
| 3. | Tannins | + | – | – | + | – | – |
| 4. | Saponins | + | – | + | + | – | – |
| 5. | Resins | + | + | + | + | + | + |
| 6. | Cardiac glycosides | + | – | + | + | + | + |
| 7. | Steroids | + | – | – | + | + | + |
| 8. | Te Terpinoids | + | + | + | + | – | + |
Note: “+”=Present, “-”=Absent
The ethanol extracts of Tagetus erecta L. has shown alkaloids, flavanoids, resins and terpenoids and the ethanol extracts of Pelargonium graveolens has shown alkaloids, flavanoids, resins, cardiacglycosides and steroids. The methanol extracts of Tagetus erecta L. has revealed the presence of alkaloids, flavanoids, saponins, resins, cardiacglycosides and terpenoids. The methanol extracts of Pelrgonium graveolens has shown the presence of alkaloids, flavanoids, resins, cardiacglycosides, steroids and terpenoids
Antibacterial assay
As per antibacterial assay, among three different extracts of Tagetus erecta L. only methanol extract showed maximum inhibition zone against Xanthomonas axonopodis pv. Punicae. All other extracts of Tagetus erecta and extracts of Pelargonium graveolens have showed less inhibition activity as shown in figure 2 and table 2. This might be due to less affinity of phytochemical active ingradients of Tagetus erecta and Pelargonium graveolens to water and ethanol. Among three extracts of two different selected plants only methanol extract of Tagetus erecta L. more effective inhibitor of Xanthomonas sp. axonopodis pv. Punicae.
![]() |
Figure 2: Antibacterial activity of selected medicinal plant extracts against Xanthomonas axonopodis pv. punicae by Kirby-Bauer disc diffusion method. |
Table 2: Antibacterial activity of selected plants extracts against Xanthomonas axonopodis pv.punicae
| Plant used | Diameter of zone of inhibition (in mm) | ||
| Aqueous Extract | Ethanol Extract | Methanol Extract | |
| Tagetus erecta | 3 mm | 0 | 19 mm |
| Pelargonium graveolens | 1 mm | 1 mm | 2 mm |
| Streptomycin sulphate + tetra cycline hydrochloride | 39 mm | ||
| Copper oxy chloride | 12 mm | ||
The previous workers reported the anti bacterial activity of different medicinal plant extracts against different species of Xanthomonas. Babu et al., in 2007 reported that Origanum vulgare and Althea officinalis are potential candidate plants for the management of phytopathogenic Xanthomonas sp.15
Bharadwaj et al., in 2011 has reported that the leaves, stem, flowers and fruits of Azadirchata indica plant extracts showed inhibitory effects on growth of Xanthomonas campestris.9
Minimum Inhibitory and Bactericidal Concentration
As only methanol extract of Tagetus erecta L. showed significantly high inhibitory activity against Xanthomonas pv punicae, the minimum inhibitory and bactericidal concentration studies were done only for this extract. The MIC and MBC values are shown in table 3. Previous studies reported the MIC and MBC assays of different plant extracts on different bacteria. Kang et al., in 2011 have also conducted the MIC and MBC of methanol and of medicinal plants against Gram-positive (5 strains) and Gram-negative bacteria which showed the highest zone of inhibition in methanol extract.13 This study demonstrates the presence of phytochemical constituents is responsible for this inhibitory activity. Application of medicinal plants as biocontrol agents is promising strategy for efficient control of bacterial blight disease.
![]() |
Figure 3: (a) MIC and (b) MBC Tagetus erecta L methanol extracts against Xanthomonas axonopodis.pv punicae |
Table 3: MIC and MBC of the Tagetus erecta L. methanol extract
| Sl. No. | Bacteria | MIC (mg/ml) | MBC (mg/ml) |
| 1. | Xanthomonas axonopodis pv.punicae | 25mg/ml | 50mg/ml |
Conclusion
There is an increasing interest in the scientific research for medicinal plants because of their potential applications in medicines and plant disease control measures. Considering the wide variety of plants, it is anticipated that scientific testing of plant extracts for antibacterial activity will lead to the discovery of new antibacterial compounds. The current study findings provide a scientific basis for traditional application of Tagetus erecta L in controlling the diseases. However, further work on these medicinal plants is required to determine their active phytochemical constituent, which is inhibitory to Xanthomonas axonopodis pv.punicae. The antibacterial activity could be increased if active components are obtained in purified form.
There is an increasing interest in the scientific research for medicinal plants because of their potential applications in medicines and plant disease control measures. An attempt was made to study the antibacterial property of two selected medicinal plants namely Tagetus erecta L. and Pelargonium graveolens against Xanthomonas axonopodis pv. punicae. The current study findings provide a scientific basis for traditional application of Tagetus erecta L extract in controlling the pomegranate diseases. However, further work on this medicinal plant is required to determine their active phytochemical constituent, which is inhibitory to Xanthomonas axonopodis pv. punicae. The antibacterial activity could be increased if active components are obtained in purified form. Further work aimed at HPLC analysis of Tagetus erecta methanol extract.
Acknowledgment
I would like to thank Dr. Lingannaiah and Prof. R. K. Rangaswamy, faculty of the Department of Botany, Government science college, Chitradurga for helping in identification of plants.
Conflict of Interest
The authors declare that they have no competing interest.
Funding Sources
The author(s) received no financial support for the research, authorship, and/or publication of this article.
References
- Singh N.V., Sharma J., Dongare M.D., Gharate R., Chinchure S., Nanjundappa M., Parashuram, S., Patil, P.G., Babu K.D., Mundewadikar D.M., Salutgi U., Tatiya M., Kumar A., Marathe R.A. In Vitro and In Planta Antagonistic Effect of Endophytic Bacteria on Blight Causing Xanthomonas axonopodis punicae: A Destructive Pathogen of Pomegranate Microorganisms, (2023);11:5
CrossRef - Gargade V.A, Kadam D.G. Screening of antibacterial activity of Ricinus communis leaves extracts against Xanthomonas axonopodis pv. Punicae. International Journal of Advanced Research in Biological Sciences. Int. J. Adv. Res. Biol. Sci., 2(9): (2015): 47-51
- Pushpa D, Pavan K, Raghavendra G, Abhishek A. Gowda, Veeresh L, Parvati P,C, Girigowda M. Reliable and early diagnosis of bacterial blight in pomegranate caused by Xanthomonas axonopodis punicae using sensitive PCR techniques. Scientific Reports. (2019); 9:10097-10106.
CrossRef - Benagi V.I., Ravi Kumar M.R., Present status of pomegranate bacterial blight and its management ISHS ACTA Horticulturae 890: II International symposium on pomegranate and Minor – including Mediterranean – Fruits (2009).
- Kuldeep K.S., Jyotsana S., Vilas T.J. Status of Bacterial Blight of Pomegranate in India.
Fruit, Veg. Cereal Sci. Biotech. (2010); 4 (2):102-105 - Benagi, V., Ravikumar, M.R., Nargund, V.B. Threat of bacterial blight on pomegranate in India– Mitigation by an integrated approach Options Mediterran Èennes, A, no. 103, II International Symposium on the Pomegranate (2012).
- Bharadwaj S.K., Laura J.S. Antibacterial activity of some plant extracts against plant pathogenic bacteria Xanthomonas compestris pv. compestris”. Agricultural research communication centre 2009; 43(1):26-31
- Singh Y., Gupta A., Kannojia P. Tagetes erecta (Marigold) – A review on its phytochemical and medicinal properties Curr Med Drug Res, 4 (1): 2020; 1-6.
CrossRef - Hamidpour, Hamidpour S., Hamidpour M., Marshall V., Hamidpour R. Pelargonium graveolens (Rose Geranium) – A Novel therapeutic Agent for antibacterial, antioxidant, antifungal and diabetics. Archives in Cancer Research 2017, 5:134-138
CrossRef - Kang CG, Hah DS, Kim CH, Kim YH, Kim E, Kim JS. Evaluation of antimicrobial activity of the methanol extracts from 8 traditional medicinal plants. Toxicol Res. 2011; 27(1):31-36
CrossRef - Kokate CK. A text book of Practical pharmacognosy. 5th Edition, Vallabh Prakashan: New Delhi 2005; 107-111.
- Aneja, R. Experiments in Microbiology: Plant Pathology and Tissue Culture, New Delhi: 2003. Wishwa Prakashan.
- Usman H., Osuji J.C. Phytochemical and in vitro anti microbial assay of the leaf extract of Newbouldia leavis. J. Trad.CAM. 2007; 4(4): 476-480
CrossRef - Babu S., Satish S., Mohana D.C., Raghavendra M.P., Raveesha K.A. 2007. Antibacterial evolution and phytochemical analysis of some Iranian medicinal plants against plant pathogenic Xanthomonas pathovars. Agric. Technol. 2007; 3(2):307-316.